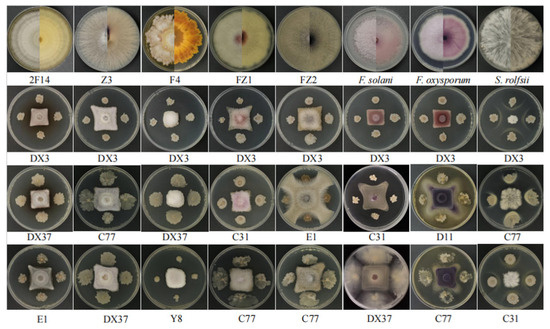
Pathogen Identification, Antagonistic Microbe Screening, and

マイストア
変更
お店で受け取る
(送料無料)
配送する
納期目安:
2025.12.10 21:45頃のお届け予定です。
決済方法が、クレジット、代金引換の場合に限ります。その他の決済方法の場合はこちらをご確認ください。
※土・日・祝日の注文の場合や在庫状況によって、商品のお届けにお時間をいただく場合がございます。
ははは56 06 07 Kawasaki Ninja ZX10 ZX10R Petrol Gas Fuel Pump Assemblyの詳細情報
06 07 Kawasaki Ninja ZX10 ZX10R Petrol Gas Fuel Pump Assembly。Amazon.com: FridayParts Throttle Motor Stepper Motor 4257163。Pathogen Identification, Antagonistic Microbe Screening, and。自転車の送料代です。コッソリ完成❣️ハイディー2 子供乗せ自転車。。よろしくお願い致します。
ベストセラーランキングです
近くの売り場の商品
カスタマーレビュー
オススメ度 4.6点
現在、6126件のレビューが投稿されています。